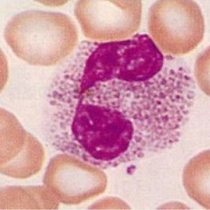

- [京都駅前耳鼻咽喉科アレルギー科クリニック]トップページ
- 鼻とアレルギーとにおいのコラム
鼻とアレルギーとにおいのコラム記事一覧
-
 【三好医師退職のお知らせ】
【三好医師退職のお知らせ】 -
 【インフルエンザ予防接種】
【インフルエンザ予防接種】 -
 7月末にくるっとパーク烏丸のみ閉鎖
7月末にくるっとパーク烏丸のみ閉鎖 -
 当院の診察時に「医療DX推進体制整備加算」が計上されます。
当院の診察時に「医療DX推進体制整備加算」が計上されます。 -
 インフルエンザ予防接種について
インフルエンザ予防接種について -
 駐車場のサービス券お渡しについて
駐車場のサービス券お渡しについて -
 5月からの外来診察のお知らせ
5月からの外来診察のお知らせ -
 外来担当表のお知らせ
外来担当表のお知らせ -
 鼻中隔弯曲症の手術をうけるのに適した時期 ~鼻の中の壁はいつ曲がっていくのか~
鼻中隔弯曲症の手術をうけるのに適した時期 ~鼻の中の壁はいつ曲がっていくのか~ -
 手術後に再発した鼻茸を伴う慢性副鼻腔炎に対する注射による治療
手術後に再発した鼻茸を伴う慢性副鼻腔炎に対する注射による治療 -
 肥厚性鼻炎に対する粘膜下下鼻甲介骨切除術:日帰りで行う鼻づまりを改善させる手術②
肥厚性鼻炎に対する粘膜下下鼻甲介骨切除術:日帰りで行う鼻づまりを改善させる手術② -
 手術実績
手術実績 -
 副鼻腔炎による嗅覚障害
副鼻腔炎による嗅覚障害 -
 重症アレルギー性鼻炎の手術:後鼻神経切断術
重症アレルギー性鼻炎の手術:後鼻神経切断術 -
 スギ花粉症に対する舌下免疫療法
スギ花粉症に対する舌下免疫療法 -
 副鼻腔炎について
副鼻腔炎について -
 好酸球性副鼻腔炎-難治性の副鼻腔炎-
好酸球性副鼻腔炎-難治性の副鼻腔炎- -
 嗅覚(におい)の障害の原因と治療
嗅覚(におい)の障害の原因と治療 -
 手術ガイド:当院での手術の流れ
手術ガイド:当院での手術の流れ -
手術ガイド:手術にかかる費用
手術ガイド:手術にかかる費用

